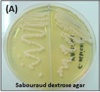

Vulvovaginite, cervicite e DIP Flashcards
(94 cards)
GO: Vulvovaginite, cervicite e DIP
Menacme fisiológico
pH vaginal? Teste das aminas? Células encontradas?
- pH 3,5-4,5;
- Teste das aminas negativo;
- Células escamosas/raros polimorfonucleares.
GO: Vulvovaginite, cervicite e DIP
Espécie bacteriana predominante na microbiota vaginal normal?
Lactobacillus sp.

GO: Vulvovaginite, cervicite e DIP
V ou F?
Fazem parte da microflora vaginal: Mycoplasma hominis, Candida albicans, Gardnerella vaginalis e Chlamydia trachomatis.
Falso.
Fazem parte da microflora vaginal: Mycoplasma hominis, Candida albicans, Gardnerella vaginalis exceto Chlamydia trachomatis.
GO: Vulvovaginite, cervicite e DIP
Vaginose bacteriana é a vaginite decorrente de uma alteração complexa da flora vaginal, com __________ (aumento/diminuição) de lactobacilos __________ (aumento/diminuição) de anaeróbios.
Diminuição; aumento.

GO: Vulvovaginite, cervicite e DIP
Vaginose bacteriana
Agente etiológico?
Gardnerella vaginalis.

GO: Vulvovaginite, cervicite e DIP
Vaginose bacteriana
Diagnóstico?
Critérios de AMSEL (3 de 4), e/ou teste de Nugent (Gram).
GO: Vulvovaginite, cervicite e DIP
Vaginose bacteriana
Diagnóstico padrão-ouro pelo MS?
Teste de Nugent.
“nugent = nojento = cheiro ruim”
GO: Vulvovaginite, cervicite e DIP
Vaginose bacteriana
Critérios de AMSEL? (4)
3 de 4 fecha o diagnóstico:
- Acinzentado, branco, fino e homogêneo (corrimento);
- Maior que 4,5 (pH);
- “Sélulas-chave” (clue cells/células-alvo);
- Lembra “peixe podre” (teste das aminas KOH / Whiff +).

GO: Vulvovaginite, cervicite e DIP
Vaginose bacteriana
Odor típico do corrimento?
“Peixe podre”.

GO: Vulvovaginite, cervicite e DIP
Vaginose bacteriana
Aminas? (3)
- Cadaverina;
- Putrescina;
- Trimetilamina.
GO: Vulvovaginite, cervicite e DIP
Vaginose bacteriana
Opções terapêuticas? (5)
- Metronidazol 500 mg, VO, 12/12h, por 7 dias;
- Metronidazol 2g, VO, dose única;
- Metronidazol gel 0,75%, 5 g, vaginal, por 5 noites;
- Clindamicina 300 mg, VO, 12/12h, por 7 dias;
- Clindamicina creme 2%, 5 g, vaginal, por 7 noites.
GO: Vulvovaginite, cervicite e DIP
Vaginose bacteriana
Tratamento para gestantes?
(1º tri e a partir do 2º tri)
Metronidazol 250mg, 2cp VO, 12/12h por 7 dias OU metronidazol gel vaginal 100mg/g, 1 aplicador cheio, via vaginal, ao deitar, por 5 dias.
(independente do trimestre)
GO: Vulvovaginite, cervicite e DIP
V ou F?
Para o MS, o tratamento da vaginose bacteriana em gestantes é feito com metronidazol em qualquer trimestre.
Verdadeiro.
GO: Vulvovaginite, cervicite e DIP
Vaginose bacteriana
Tratamento para alérgicas ao metronidazol?
Clindamicina creme 2% 5g, vaginal, por 7 noites OU clindamicina 300 mg, VO, 12/12h, por 7 dias.

GO: Vulvovaginite, cervicite e DIP
V ou F?
O acompanhamento clínico da vaginose bacteriana só é feito se houver múltiplas recorrências.
Verdadeiro.
GO: Vulvovaginite, cervicite e DIP
V ou F?
A presença de Gardnerella vaginalis no exame de preventivo em paciente assintomática tem indicação de tratar.
Falso.
A presença de Gardnerella vaginalis no exame de preventivo em paciente assintomática não tem indicação de tratar. Deve-se tratar somente se sintomática.
GO: Vulvovaginite, cervicite e DIP
V ou F?
Na vaginose bacteriana, deve-se tratar o parceiro na ausência de sintomas.
Falso.
Na vaginose bacteriana, não há necessidade de tratar o parceiro na ausência de sintomas.
GO: Vulvovaginite, cervicite e DIP
Candidíase
Agente etiológico?
Candida sp.
(Albicans é a mais frequente)

GO: Vulvovaginite, cervicite e DIP
Na candidíase vaginal, os lactobacillus encontram-se _________ (aumentados/diminuídos) e os leucócitos, _________ (aumentados/diminuídos).
Diminuídos; aumentados.
GO: Vulvovaginite, cervicite e DIP
Candidíase
Clínica? (7)
CANDIDA
- Corrimento branco aderido, em nata;
- Abaixo de 4,5 (pH);
- Negativo (teste das aminas);
- Dispareunia;
- “Ifas” (pseudo-hifas no exame à fresco com KOH);
- Disúria/hiperemia vulvar;
- Ardor/prurido.

GO: Vulvovaginite, cervicite e DIP
V ou F?
Se pH < 4,5 será fisiológico, candidíase ou vaginose citolítica.
Verdadeiro.
“fisiológico ou os ‘C’s: Candidíase ou Citolítica”

GO: Vulvovaginite, cervicite e DIP
Candidíase
Se microscopia negativa, qual exame pedir?
Meio de cultura Ágar Sabouraud ou Nickerson.
GO: Vulvovaginite, cervicite e DIP
Na candidíase o tratamento do parceiro é ________ (obrigatório/dispensável).
Dispensável.
(pode ser parte da microbiota normal)
GO: Vulvovaginite, cervicite e DIP
Candidíase
Tratamento? (4)
- Miconazol por 7 noites;
- Nistatina por 14 noites;
- Clotrimazol por 7 noites;
- Fluconazol 150 mg, VO, dose única.
(cremes imidazólicos tópicos são a 1ª linha)

























